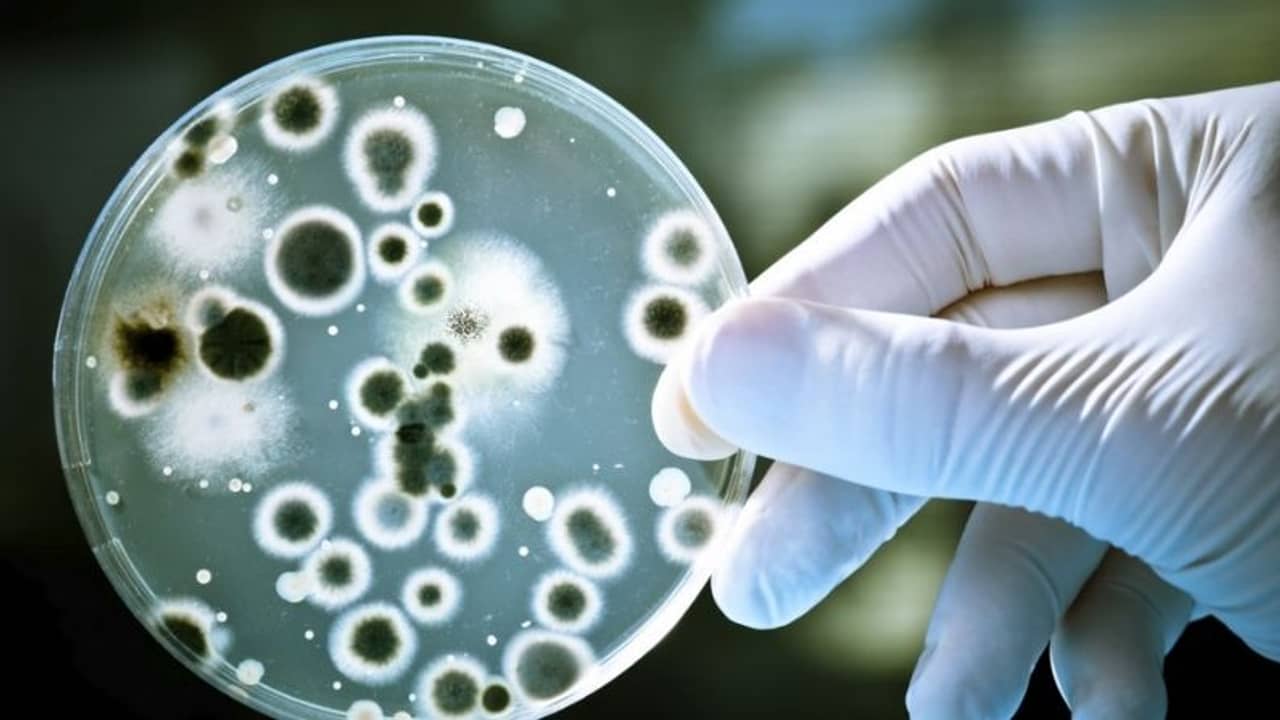

গ্রানাডা: ভ্যাকসিন নিয়ে সুখবর আসলেও করোনা নিয়ে ভয় কাটেনি। এর মধ্যেই চাঞ্চল্যকর তথ্য প্রকাশিত হয়েছে অ্যাটমোস্ফেরিক রিসার্চ জার্নালে। সেখানে গবেষকরা দাবি করছেন জলবায়ুগত ধূলিকনার মাধ্যমে এক মহাদেশ থেকে অন্য মহাদেশে চলে যেতে পারে কিছু ব্যাকটেরিয়া (Bacteria)। আর সেই ব্যাকটেরিয়া শুধুমাত্র মানব দেহে প্রভাব বিস্তার করে না, পাশাপাশি ক্ষতিগ্রস্ত করে বাস্তুতন্ত্র ও জলবায়ুতেও।
গ্রানাডা ইউনিভার্সিটির গবেষকদের মতে অ্যারোসোলের মাধ্যমে ছড়িয়ে পড়ে ব্যাকটেরিয়া। তাদের মতে অ্যারোসোলগুলি ব্যাকটেরিয়ার বাহক হিসাবে কাজ করে। গবেষকরা জানিয়েছেন, প্রত্যেকটি বায়োঅ্যারোসোলে বিভিন্ন ধরনের খনিজ ও অনেক ক্ষুদ্রাকার বস্তু থাকে।
আরও পড়ুন: সকাল হলেই টিকাকরণ! আমেরিকার প্রত্যেকটি হাবে প্রস্তুতি তুঙ্গে
গবেষক মলিনারো গার্সিয়া জানিয়েছেন, বায়োঅ্যারোসোলগুলিতে ব্যাকটেরিয়া বেঁচে থাকতে পারে কারণ অ্যারোসোলগুলির মধ্যে ব্যাকটেরিয়ার প্রয়োজনীয় সব উপাদান থাকে। তাদের বিশ্বাস এই ধূলিকনা জাতীয় পদার্থের মাধ্যমে ব্যাকটেরিয়া বিশ্বের বিভিন্ন প্রান্তে ঘুরে বেড়াতে পারে। যার অন্যতম উদাহরণ সাহারার এয়ার লেয়ার যাকে সংক্ষেপে সেল বলা হয়।